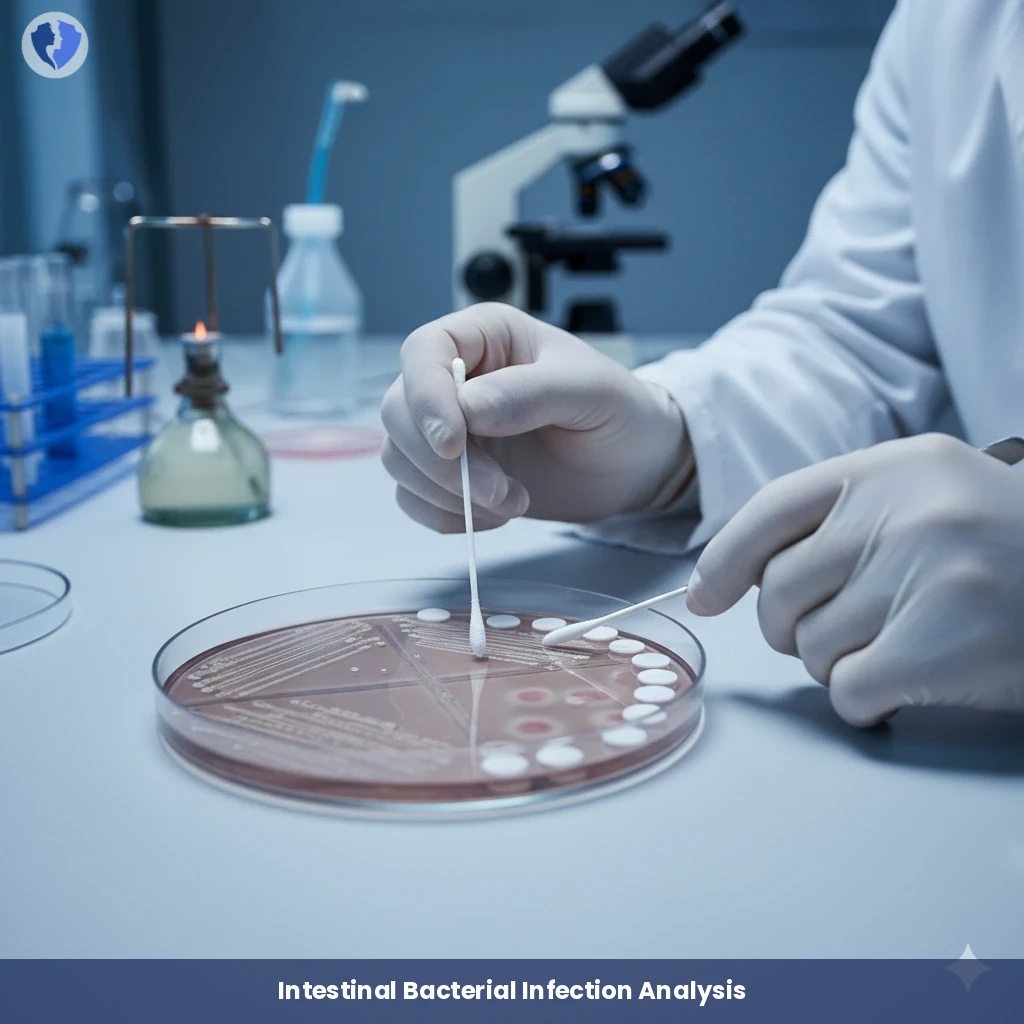
Rectal Swab Culture

Service Details
Rectal Swab Culture
A diagnostic microbiological examination in which a sample is collected from inside the rectum using a special sterile swab. The sample is cultured on a range of selective and differential media for the initial isolation of pathogenic enteric bacteria. The primary goal is to isolate and identify bacterial pathogens (such as Salmonella, Shigella, Campylobacter, and Escherichia coli), and to perform an antibiogram (antibiotic susceptibility test) to guide treatment. It is also used to detect carriers of resistant bacteria, such as CRE or MRSA, in the rectum.